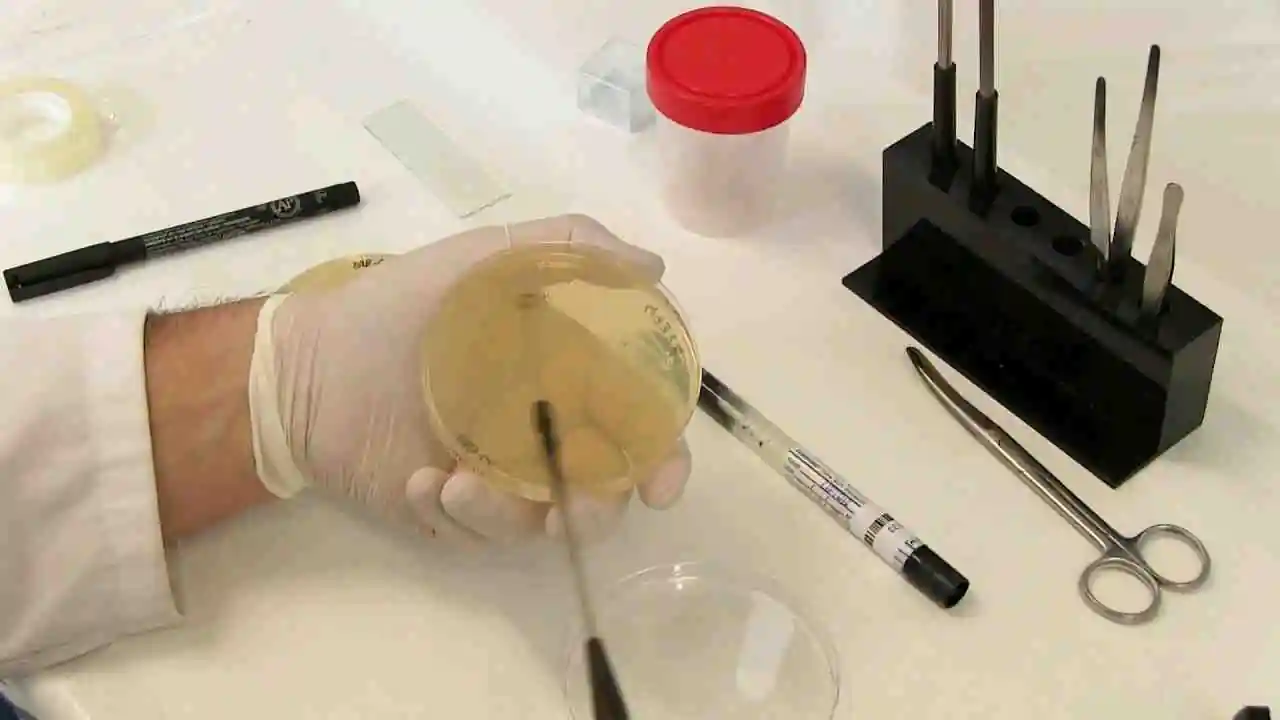
Sedimento Urinario + Urocultivo

Especialización en Análisis de Orinas: Sedimento Urinario y Urocultivo
El análisis de orina sigue siendo una de las pruebas de tamizaje más solicitadas y valiosas en el laboratorio clínico. Sin embargo, la correcta interpretación del sedimento urinario y la validación de un urocultivo requieren una formación técnica rigurosa para evitar resultados falsos positivos o interpretaciones erróneas que afecten el tratamiento del paciente. https://www.sadi.org.ar/
Este Curso de Sedimento Urinario + Urocultivo es una formación integral diseñada para fortalecer las competencias clínicas y diagnósticas. Abordamos desde los fundamentos del examen general de orina (EGO) hasta la identificación avanzada de patógenos, integrando técnicas actualizadas y los criterios diagnósticos más recientes para la infección urinaria (ITU). https://virtuallabint.com/cursos-laboratorio-clinico-online/
La Importancia Clínica del Sedimento Urinario
El sedimento urinario es, en esencia, una «biopsia líquida» del sistema renal. A través del microscopio, el profesional puede identificar elementos formes que revelan el estado funcional de las nefronas. En este curso, profundizamos en la identificación de cristales, cilindros, células epiteliales y la presencia de leucocituria o hematuria dismórfica, un signo clave en las patologías glomerulares.
Dominar el sedimento urinario permite al bioquímico y al técnico de laboratorio aportar un valor añadido al informe médico, diferenciando una simple contaminación de una patología real. La observación minuciosa bajo protocolos estandarizados (como los de las guías CLSI) es el eje central de nuestra capacitación.
Del Examen General al Urocultivo
Un análisis completo no se detiene en la microscopía. El complemento ideal del sedimento urinario es el urocultivo cuando existe sospecha clínica de infección. Durante el módulo de microbiología, los estudiantes aprenderán:
-
Fase Pre-analítica: La importancia de la correcta toma de muestra para evitar la microbiota comensal.
-
Siembra y Recuento: Técnicas de siembra por técnica de asa calibrada y el recuento de unidades formadoras de colonias (UFC).
-
Identificación de Patógenos: Estudio de las enterobacterias más comunes, como Escherichia coli, y cocos gram positivos.
-
Antibiograma: Interpretación básica de la sensibilidad antibiótica para orientar el tratamiento.
Metodología de Virtual Lab: Casos Clínicos Reales
En Virtual Lab, creemos que la teoría debe ir de la mano con la práctica. Por ello, el curso utiliza casos clínicos reales donde la correlación entre el sedimento urinario (presencia de nitritos o bacterias) se analiza junto con los resultados del cultivo. Este enfoque holístico es lo que define a un profesional de laboratorio de excelencia.
Nuestro material está actualizado con base en fuentes de autoridad académica, incluyendo las guías internacionales y textos clásicos como Bacteriología General de Hans G. Schlegel, asegurando que la formación tenga un respaldo científico sólido.
¿A quién va dirigido este curso?
Esta capacitación está diseñada para profesionales de laboratorio clínico, bioquímicos, médicos generales, estudiantes de ciencias de la salud y técnicos en diagnóstico clínico que deseen actualizar sus conocimientos en el área de uroanálisis. Al ser un curso 100% online, gratuito y con certificación opcional, ofrece la flexibilidad necesaria para el profesional en actividad.
Para aquellos interesados en ampliar su perfil profesional, recomendamos visitar nuestra sección de [Cursos de Bacteriología y Microbiología] (pon aquí tu link interno), donde podrán profundizar en otras áreas del diagnóstico infeccioso. Además, pueden consultar las normativas de la Sociedad Argentina de Bacteriología (pon aquí tu link externo) para estar al día con los últimos consensos.
Beneficios de capacitarse en Virtual Lab
Dominar el estudio del sedimento urinario y urocultivo te permitirá reportar con mayor seguridad y precisión. En un entorno donde la resistencia antibiótica es una preocupación creciente, el rol del analista en el diagnóstico preciso de infecciones urinarias es más vital que nunca. ¡Inscríbete hoy y comienza a perfeccionar tu técnica de lectura!

Valoraciones
No hay valoraciones aún.